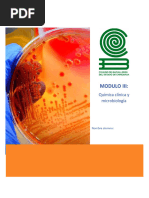

0% encontró este documento útil (0 votos)
80 vistas15 páginasPráctica de Toxicología Ambiental: Fundamentos
Este documento presenta la guía para una práctica de laboratorio sobre conceptos básicos de toxicología. La práctica se enfocará en generalidades sobre concentración, dosis y tiempo de exposición. Se llevará a cabo en el laboratorio A-101 durante 2 horas en grupos de 4 estudiantes. La guía incluye competencias, marco teórico, consulta previa, palabras clave y metodología. El marco teórico explica conceptos clave como dosis, lipofilicidad, tamaño y variabilidad individual.
Cargado por
Gian Franco ValenciaDerechos de autor
© © All Rights Reserved
Nos tomamos en serio los derechos de los contenidos. Si sospechas que se trata de tu contenido, reclámalo aquí.
Formatos disponibles
Descarga como DOCX, PDF, TXT o lee en línea desde Scribd
0% encontró este documento útil (0 votos)
80 vistas15 páginasPráctica de Toxicología Ambiental: Fundamentos
Este documento presenta la guía para una práctica de laboratorio sobre conceptos básicos de toxicología. La práctica se enfocará en generalidades sobre concentración, dosis y tiempo de exposición. Se llevará a cabo en el laboratorio A-101 durante 2 horas en grupos de 4 estudiantes. La guía incluye competencias, marco teórico, consulta previa, palabras clave y metodología. El marco teórico explica conceptos clave como dosis, lipofilicidad, tamaño y variabilidad individual.
Cargado por
Gian Franco ValenciaDerechos de autor
© © All Rights Reserved
Nos tomamos en serio los derechos de los contenidos. Si sospechas que se trata de tu contenido, reclámalo aquí.
Formatos disponibles
Descarga como DOCX, PDF, TXT o lee en línea desde Scribd